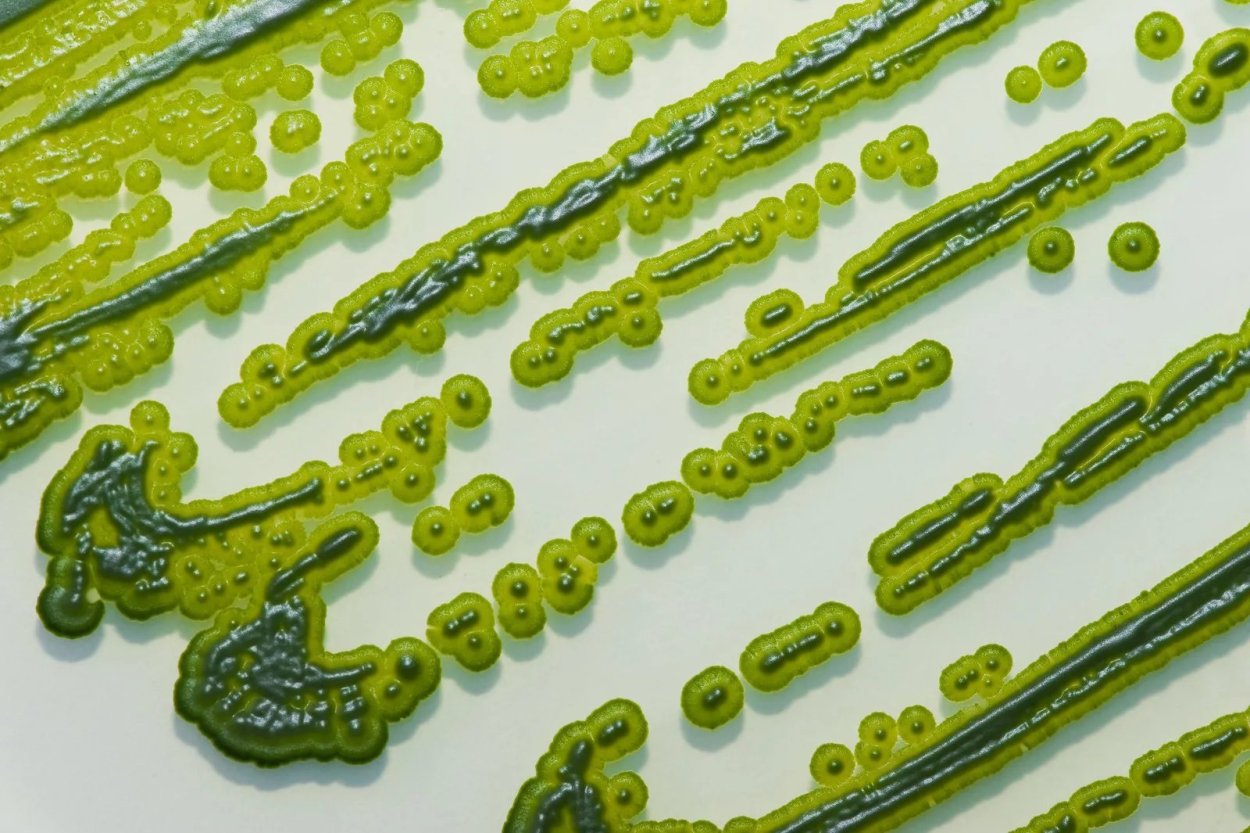
Носток цианобактерия

Микроцистис водоросль

Сине-зеленые водоросли (Cyanophyta)

Цианобактерии носток Анабена

Зеленые водоросли ботаника

Макроцистис пирифера

Ламинария макроцистис

Анабена и носток

Nostoc цианобактерия

Макроцистис водоросли

Бурые водоросли макроцистис

Водоросли коллаж

Цветение воды цианобактерии

Кораллы царство

Спирулина сине зеленая водоросль

Водоросли Северного Ледовитого океана

Arthrospira platensis

Макроцистис грушевидный

Охрофитовые водоросли

Бурые водоросли агарум

Сине-зеленые водоросли цианобактерии

Бурые водоросли макроцистис

Цианобактерии микроцистис

Подводный "лес"(Kelp Forest)

Гетерактис Магнифика

Бурые водоросли макроцистис

Ламинария макроцистис

Сине-зеленые водоросли цианобактерии

Диктиота водоросль

Macrocystis pyrifera

Цианобактерии микроцистис

Синезеленые водоросли

Саргассово море бурые водоросли

Макроцистис и хлорелла

Кодиум водоросль

Микроцистис водоросль

Цианобактерии микроцистис

Микроцистис водоросль

Ундария перистая

Ламинария макроцистис
Носток цианобактерия

Microcystis aeruginosa

Масло водорослей

Келп водоросли

Coleochaete pulvinata

Макроцистис пирифера

Микроцистис (Microcystis)

Макроцистис пирифера

Морская капуста с фукусом

Одноклеточные цианобактерии

Цианобактерия Oscillatoria

Microcystis aeruginosa микроскоп

Microcystis pulverea

Носток водоросль

Бурые водоросли макроцистис

Макроцистис водоросли

Бурые водоросли макроцистис

Galaxaura filamentosa водоросли

Макроцистис водоросли

Морские водоросли Эстетика

Микроцистис водоросль

Цианобактерии в море

Краб в водорослях

Мерисмопедия водоросль

Цианобактерия Anabaena

Растения